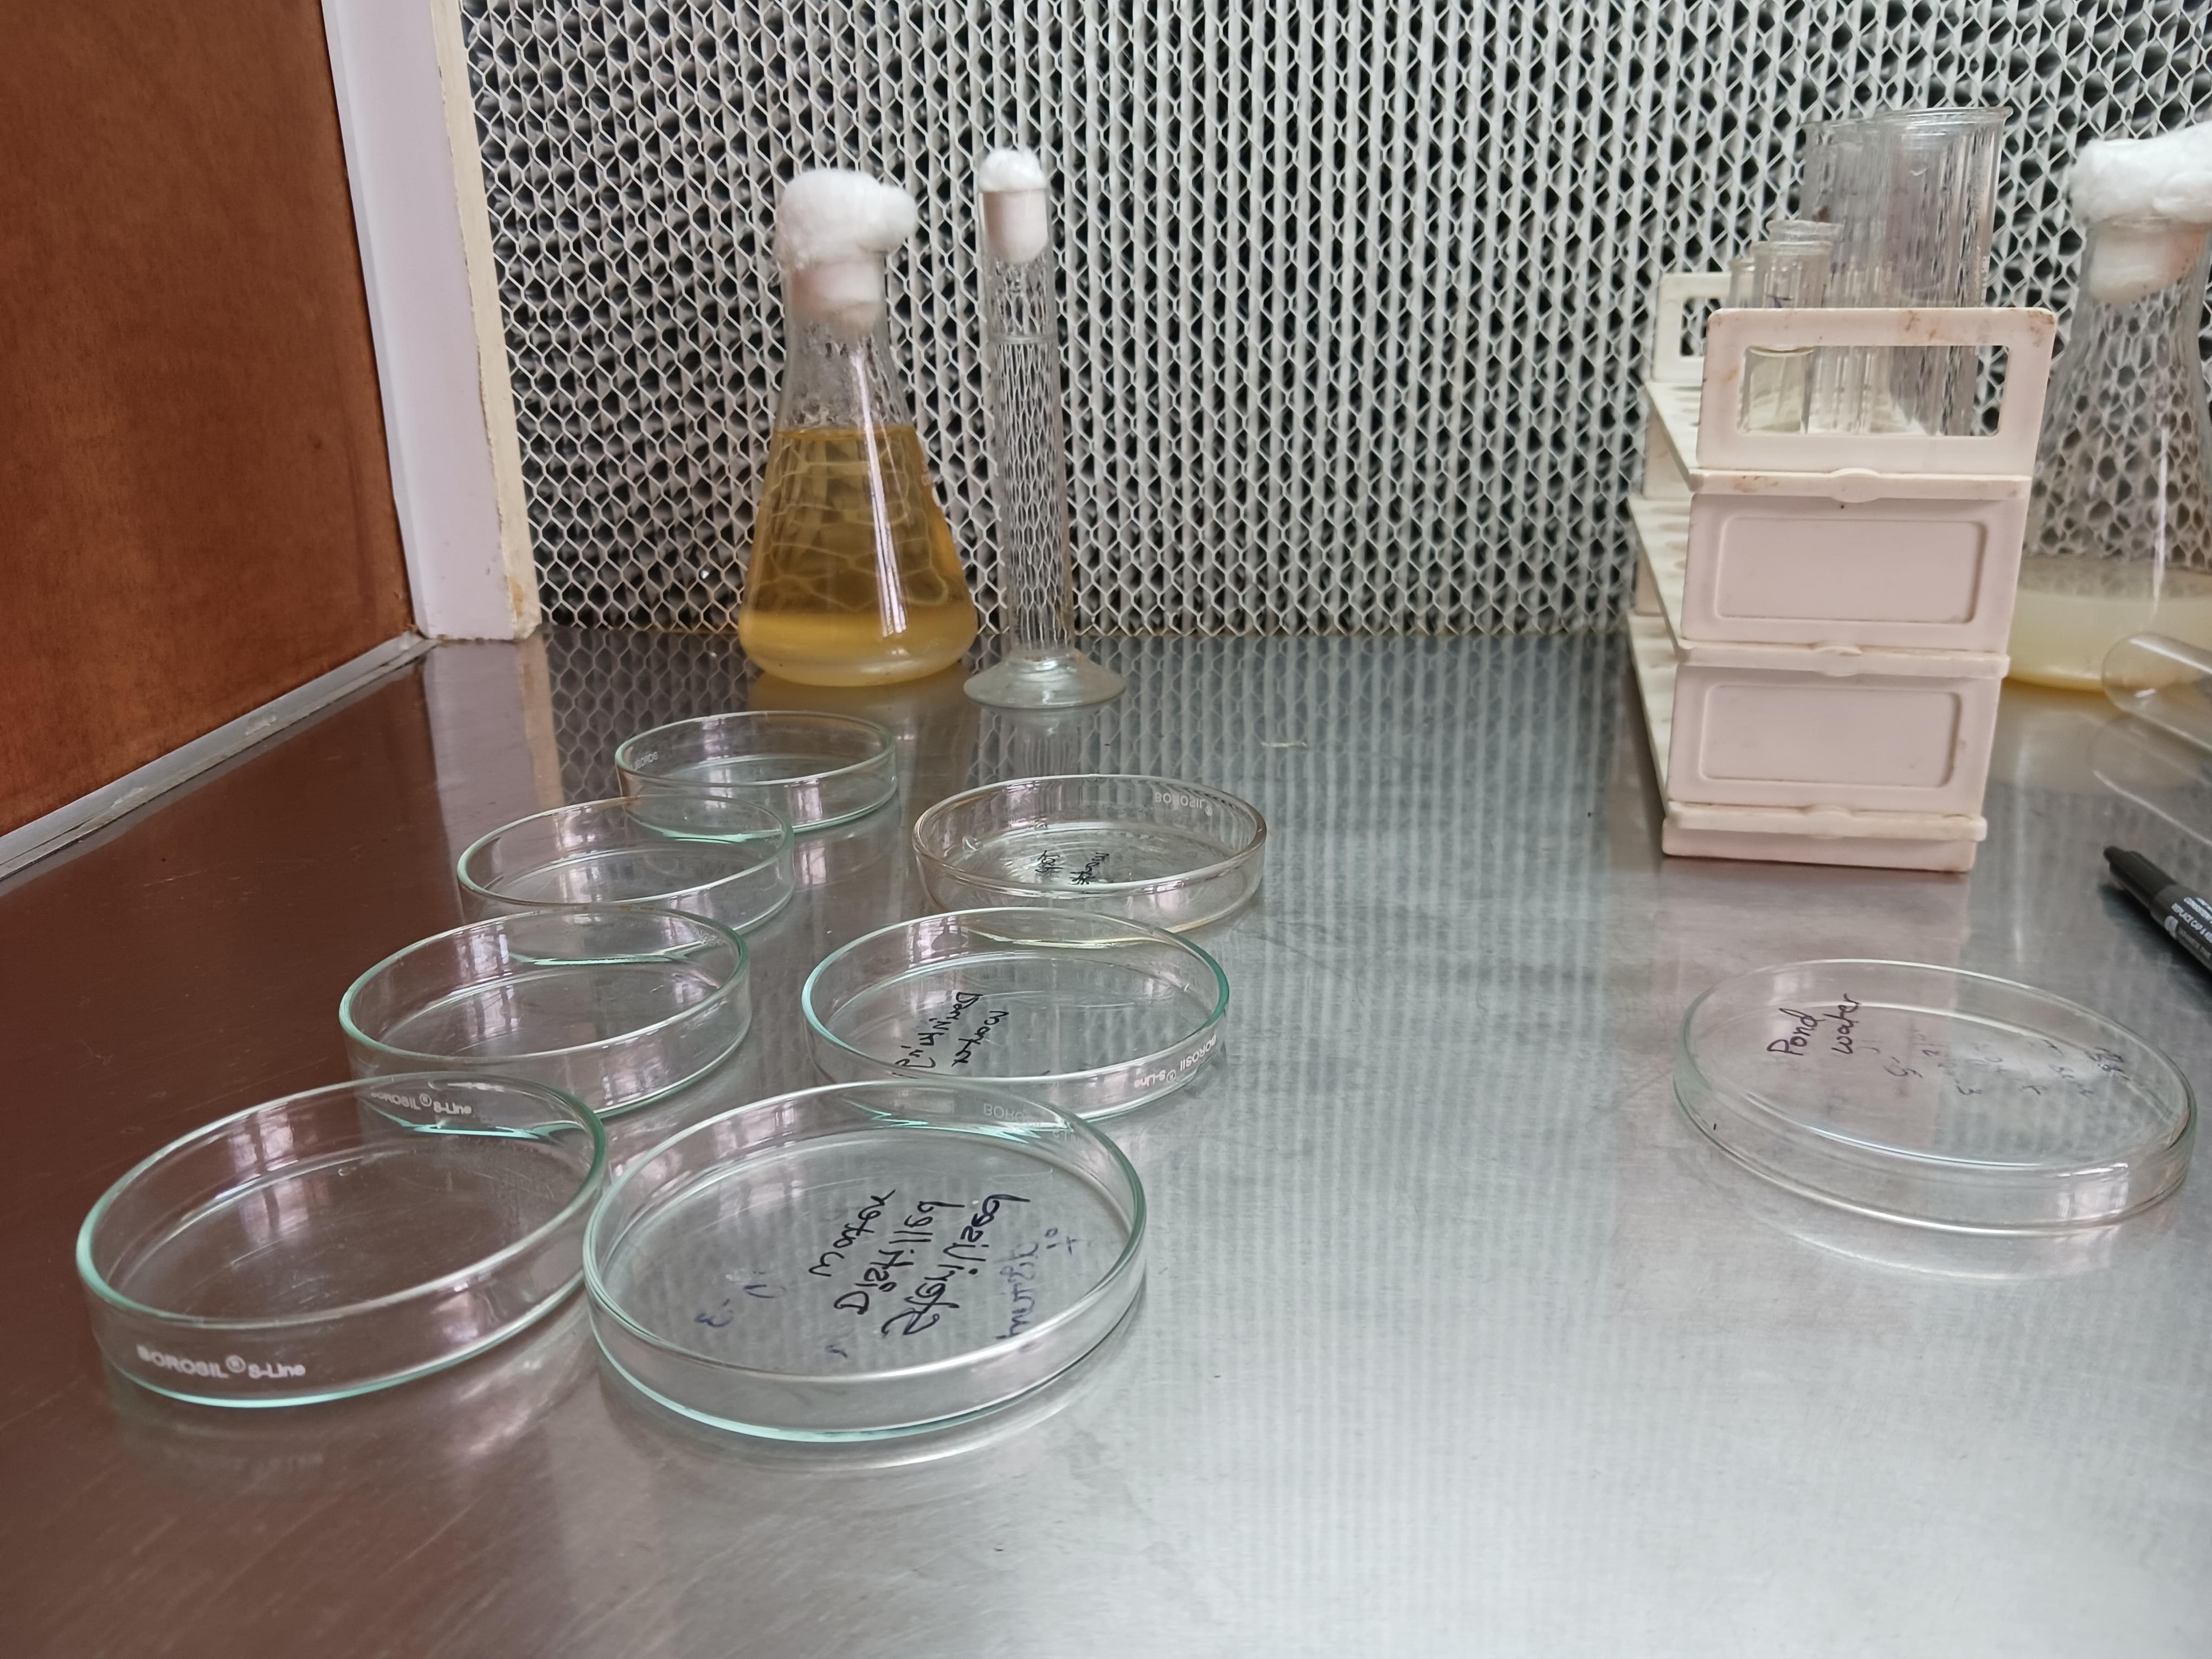

The college offers moderate placement opportunities with some top companies visiting annually, such as Wipro, Infosys, Amazon, and Mahindra. The highest reported package for B.Com students is approximately 7 lakh per annum. However, many students find placements through off-campus efforts, as on-campus placement rates are average and often require students to be rank holders or university blue.
Internships are available, with some students earning stipends, such as 5k per month. Placement drives and internship workshops are organized, but often lack satisfactory packages and job profiles. The college provides training prior to graduation to improve employability. Additionally, the Karnataka Government grants scholarships annually. Overall, while opportunities exist, many students pursue additional education or off-campus opportunities to enhance their prospects.

![Rani Channamma University - [RCUB]](https://image-static.collegedunia.com/public/college_data/images/logos/uv25623.jpg?h=71.7&w=71.7&mode=stretch)

![K.N.V.V. Sangha's Arts and Commerce College Kittur - [KNVVSACCK]](https://image-static.collegedunia.com/public/college_data/images/appImage/2253_KNVV_NEW.jpg?h=111.44&w=263&mode=stretch)

![Rani Parvati Devi College of Arts and Commerce - [RPD]](https://image-static.collegedunia.com/public/college_data/images/appImage/3746_RPD_APP.jpg?h=111.44&w=263&mode=stretch)





![School of Social Science and Humanities, CMR University - [SOSSH]](https://image-static.collegedunia.com/public/college_data/images/appImage/152759203656100app.jpg?h=111.44&w=263&mode=stretch)














 (61).png?h=72&w=72&mode=stretch)


![M.P.E. Society's S.D.M. College of Arts, Science and Commerce - [SDMC]](https://image-static.collegedunia.com/public/college_data/images/logos/1426913191sdm_college_logo3.jpg?h=72&w=72&mode=stretch)
![Belgaum Institute of Management Studies - [BIMS]](https://image-static.collegedunia.com/public/college_data/images/logos/1429768235bims-logo1.jpg?h=72&w=72&mode=stretch)


![Hemchand Yadav Vishwavidyalaya - [HYV]](https://image-static.collegedunia.com/public/college_data/images/logos/1584431900dur.png?h=72&w=72&mode=stretch)

![Karnatak University - [KU]](https://image-static.collegedunia.com/public/college_data/images/logos/1514370036Logo.jpg?h=72&w=72&mode=stretch)



![Govindram Seksaria Science College - [GSSC]](https://image-static.collegedunia.com/public/college_data/images/logos/1471864815Untitled.1png.png?h=72&w=72&mode=stretch)


![People Tree Education Society - [PTES]](https://image-static.collegedunia.com/public/college_data/images/logos/1487574449logoedt.png?h=72&w=72&mode=stretch)


Comments